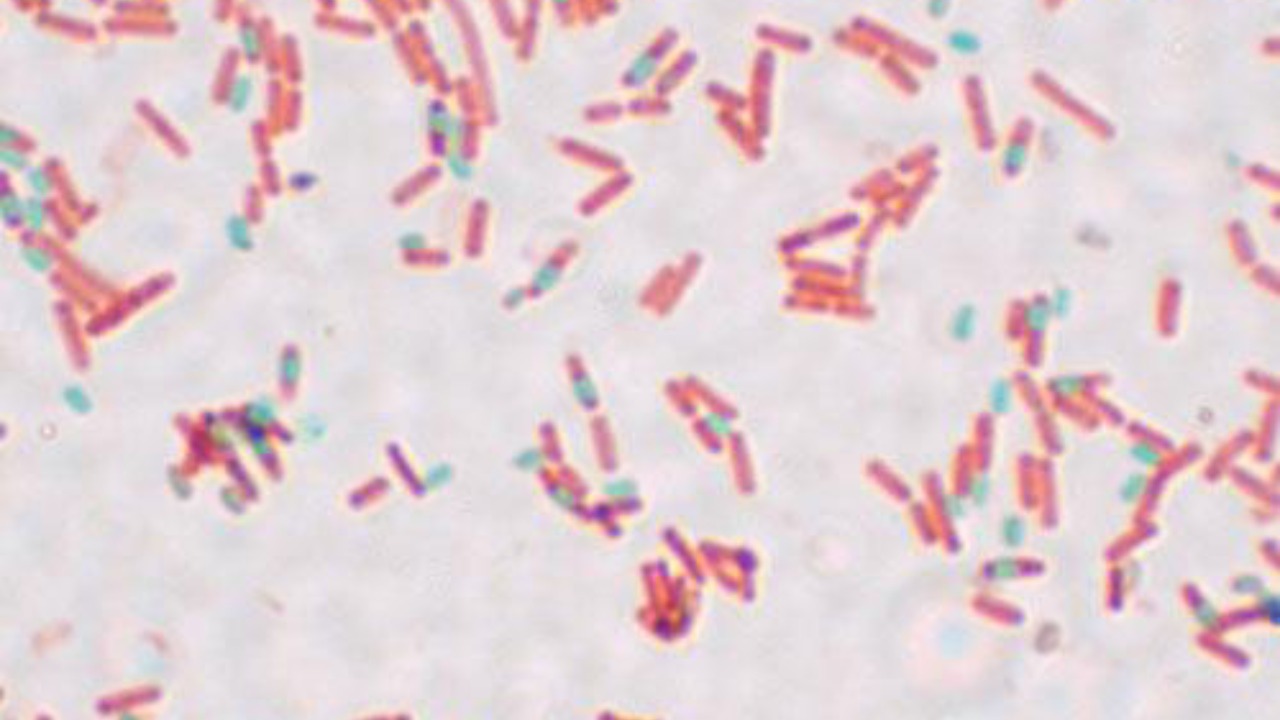

Researchers at the University of California, Davis, have made a groundbreaking discovery by exposing the human gut bacterium Bacillus subtilis to the harsh conditions of spaceflight aboard a Blue Origin New Shepard rocket. The bacterium not only survived but remained viable for potential recolonization of astronaut microbiomes. This breakthrough, detailed in a study published in npj Microgravity, highlights the microbe’s resilience without needing a human host during transit. These findings underscore the potential for maintaining essential microbial communities in space, offering hope for healthier long-term missions to the Moon or Mars (Space.com).
The Harsh Environment of Space and Microbial Challenges

Spaceflight presents a uniquely hostile environment for terrestrial life, characterized by microgravity, cosmic radiation levels up to 1,000 times higher than on Earth, and extreme temperature fluctuations ranging from -150°C to 120°C. These conditions, combined with vacuum exposure, typically prove lethal to most terrestrial microbes. Such stressors can disrupt bacterial cell walls and DNA, leading to rapid microbial death. Previous experiments have shown that non-essential microbes often fail to survive beyond a few days in low-Earth orbit (Earth.com).
Gut microbes like Bacillus subtilis play a crucial role in human digestion and immune function, making their survival during space missions vital. The isolation from hosts in space poses a significant challenge, as these microbes are vulnerable to the extreme conditions encountered during space travel. Ensuring their viability is essential for maintaining astronaut health on long-duration missions (Nature.com).
Experimental Design: Testing Bacillus subtilis in Suborbital Flight

The experiment, led by Christopher Cornmesser and his team, involved encapsulating Bacillus subtilis spores in a specialized payload launched on Blue Origin’s New Shepard rocket. This 11-minute suborbital flight reached an altitude of 107 kilometers. Ground-based simulations of space conditions served as controls, and post-flight viability assays using culturing techniques measured survival rates above 80% for the exposed samples (Gizmodo).
The spore-forming mechanism of Bacillus subtilis allows it to enter a dormant state, making it resistant to desiccation and radiation. This resilience was verified through electron microscopy of flight samples, demonstrating the bacterium’s ability to withstand the rigors of space travel. Such findings are pivotal for future missions that may rely on microbial inoculants to support astronaut health (Frontiers in Microbiology).
Key Results: Survival Rates and Mechanisms
The primary finding of the study was that Bacillus subtilis spores exhibited no significant loss in viability after exposure to space conditions, with recovery rates comparable to Earth controls. This demonstrates the bacterium’s remarkable tolerance to the combined stressors of spaceflight. The role of dipicolinic acid in spore coats was crucial, providing protection against UV and gamma radiation doses equivalent to six months on the International Space Station (Earth.com).
Comparisons to previous missions, such as the 2019 Tanpopo experiment on the ISS, reveal that while similar bacteria survived, they did so at lower rates without the suborbital isolation tested here. This highlights the importance of the specific conditions and methodologies employed in the current study, which could inform future strategies for microbial preservation in space (Space.com).
Implications for Astronaut Health and Future Space Exploration

The ability to transport viable microbes like Bacillus subtilis could prevent dysbiosis in astronauts’ guts during missions lasting over 1,000 days, reducing risks of infections and nutrient malabsorption. This is particularly relevant for NASA’s Artemis program and potential Mars missions, where pre-packaged microbial inoculants might support crew health without relying on in-situ culturing (Gizmodo).
However, the potential ethical and biosafety concerns cannot be overlooked. The risk of contaminating extraterrestrial environments with Earth-origin microbes is a significant consideration for astrobiologists. These concerns must be addressed to ensure that space exploration proceeds responsibly and sustainably, balancing the benefits of microbial transport with the need to protect other worlds (Earth.com).